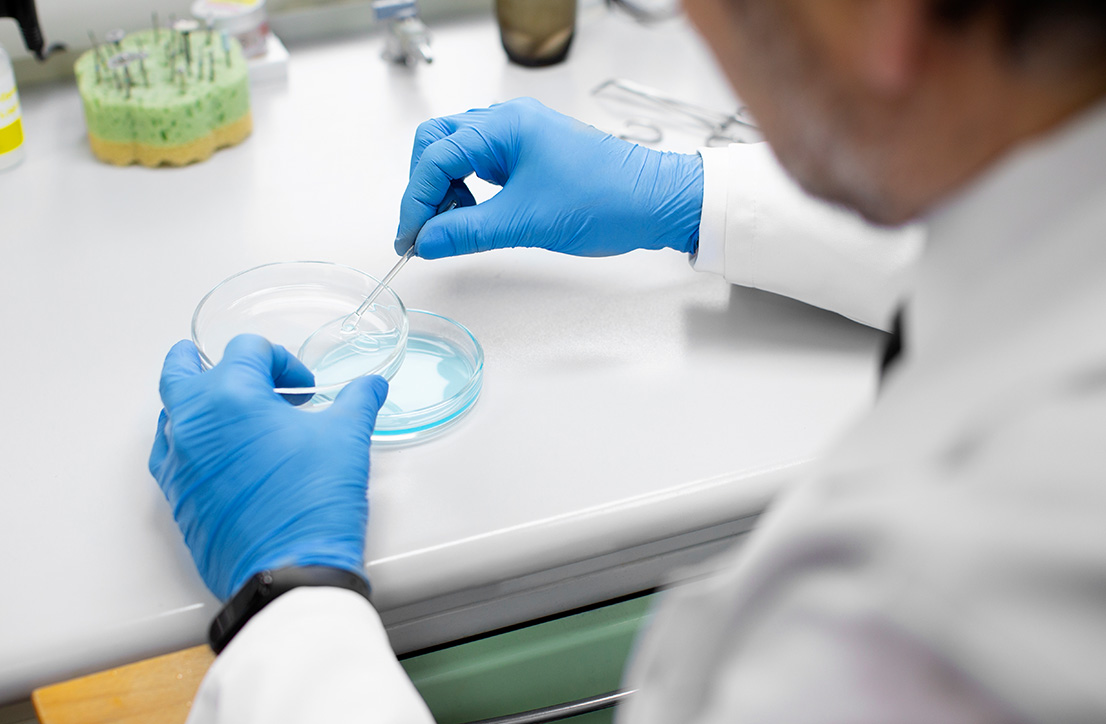

Laboratorio de Genética Molecular
Pruebas de
paternidad en Puebla
Las pruebas de paternidad son la manera más segura de confirmar un vínculo biológico entre un padre y un hijo. Hoy en día estos estudios son rápidos, accesibles y discretos, sobre todo de la mano de un equipo especializado.
Encuentra respuesta a tus dudas
Nuestro equipo de profesionales en genética pone a tu alcance pruebas de paternidad precisas y confiables, diseñadas para brindarte la certeza que necesitas. Te acompañamos en cada paso del proceso, asegurando confidencialidad, asesoría personalizada y resultados claros.
0%
Precisión en resultados
Con tecnología de última generación
+0
Marcadores genéticos
Utilizados para análisis confiables
0%
Clientes satisfechos
Por una atención de alta calidad

¿Cuándo es recomendable
realizar una prueba de paternidad?
Existen diferentes razones para considerar este tipo de prueba, tales como las siguientes:
Nunca es demasiado pronto ni demasiado tarde para realizar una prueba de paternidad; las diferentes modalidades y técnicas permiten hacerla después o antes del nacimiento, según las necesidades y contexto del paciente.
¿Qué son las
pruebas genómicas?
A diferencia de las pruebas genéticas tradicionales, las pruebas genómicas analizan el material genético del tumor, no del individuo. Estas pruebas se realizan cuando el cáncer ya ha sido diagnosticado y permiten conocer cómo se comporta genéticamente el tumor.
La información genómica es clave para definir qué tratamientos pueden ser más eficaces y predecir la respuesta del tumor a ciertas terapias.


Tipos de pruebas de paternidad en Puebla
Una prueba de ADN puede darte la tranquilidad que necesitas para tomar decisiones importantes. Pero no todas las pruebas son iguales; conocerlas te ayudará a elegir la opción que realmente se ajuste a lo que buscas.
Pruebas de paternidad informativas
Ideal si solo quieres confirmar una relación biológica de forma privada. No tiene validez legal, pero brinda total confianza en los resultados, ya que se realiza con la misma precisión científica que cualquier otra prueba de ADN.
Pruebas de paternidad legales
Si necesitas que el resultado tenga validez en trámites oficiales, esta es la opción indicada. Se utiliza sobre todo en juicios de custodia, pensión alimenticia, herencias o registros civiles.


Pruebas de paternidad prenatal
Cuando la pregunta sobre la paternidad surge durante el embarazo, la prueba prenatal permite obtener respuestas antes del nacimiento del bebé. Se trata de un proceso seguro que solo requiere una muestra de sangre de la madre y una del presunto padre.
1.- Agenda tu cita
3.- Análisis en laboratorio
5.- Asesoría adicional
2.- Toma de muestras
4.- Obtención de resultados
Realizar una prueba de paternidad es un proceso sencillo, pero entendemos que dar este paso puede generar nerviosismo. Por eso, te explicamos todo lo que necesitas saber para que te sientas tranquilo durante el procedimiento:
Los resultados son altamente fiables. Cuando la prueba se realiza en un laboratorio certificado, la precisión alcanza hasta un 99.9% en casos de inclusión y 100% en exclusión de paternidad.
Contamos con tecnología de última generación en genética molecular y estrictos protocolos de control, lo que garantiza que tus pruebas se realicen y concluyan con la máxima precisión.

Ventajas de realizar una prueba de paternidad en Puebla
Cada etapa del proceso de pruebas de paternidad está diseñada pensando en ti. Nuestro objetivo es brindarte tranquilidad desde el primer momento. Al realizar una prueba de paternidad, obtienes:
Procedimiento sin complicaciones
El procedimiento es completamente indoloro. Solo se necesita un hisopado bucal para recolectar la muestra, sin agujas ni procedimientos invasivos. En cuestión de minutos estarás listo, y el resto del trabajo lo realizarán los especialistas en laboratorio. Esto hace que la prueba sea accesible para personas de cualquier edad, desde recién nacidos hasta adultos.
¿Más preguntas?
Certeza científica garantizada
La tecnología de análisis genético utilizada en nuestros laboratorios permite obtener resultados con un nivel de precisión que elimina cualquier margen de duda. Con más de 20 marcadores analizados, se asegura un alto porcentaje de certeza.
Una solución para cada necesidad
Nuestra misión es que cada persona obtenga exactamente la información que necesita, con la discreción que merece. Por ello, cada uno de nuestros servicios está diseñado para ser flexible, adaptándose a tu situación y garantizando resultados confiables en todo momento.
Privacidad asegurada
Nos aseguramos de proteger tu información en cada fase. Desde la toma de la muestra hasta la entrega del informe, la discreción es absoluta. Nadie más que tú tendrá acceso a los datos. Esto te permite vivir la experiencia con total tranquilidad, sabiendo que tu decisión se mantiene dentro de un espacio seguro.
Acompañamiento profesional
Más allá de la tecnología, está el trato humano. Durante el servicio contarás con especialistas que te guían, aclaran tus dudas y te acompañan con profesionalismo. La combinación de ciencia, experiencia y atención cercana convierte este servicio en una experiencia segura..
¿Más preguntas?
Teléfono
Contáctanos
Si te interesa conocer más sobre nuestros servicios de pruebas genéticas de cáncer, pruebas genómicas, pruebas de paternidad, pruebas de tamiz, entre otros tipos de estudios, te recomendamos ponerte en contacto con nosotros.